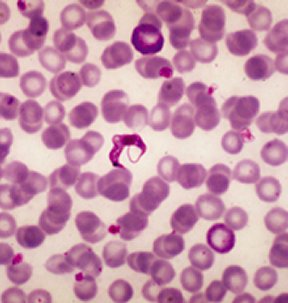

Invasive Genes: Humans incorporate DNA from parasite
The “us-against-them” mindset may take on new meaning when applied to infections by the parasitic protozoan Trypanosoma cruzi. New research shows that bits of foreign DNA from the parasite become integrated into the DNA of an infected person. This is the first time that parasitic DNA has been found in the human genome, says Antonio Teixeira of the University of Brasilia in Brazil.
“This is a very new idea, and as such it will be controversial,” says parasitologist David A. Campbell of the University of California, Los Angeles, who was not involved in the study. “It’s surprising, but I’m convinced by the data.”
More than 16 million people in South America are infected with T. cruzi, the causative agent of Chagas’ disease, and 50,000 people die of the disease there each year. Most contract the chronic disease early in life with little serious effect at that time. Decades later, 30 percent of infected people suffer damage to vital organs, most notably the heart. Many other biological details of the disease remain a mystery.
Teixeira and his team analyzed the DNA of 13 adults with heart damage from Chagas’ disease. The researchers found pieces of DNA from the parasite within the genome of each patient, primarily at a specific location on chromosome 11, the researchers report in the July 23 Cell.
A parasite’s DNA is called kinetoplast-DNA (kDNA), and it’s not normally present in multicellular organisms. “It pollutes the human genome,” Teixeira says of T. cruzi‘s kDNA.
To confirm that kDNA can get into chromosomes, Teixeira turned to chickens, which don’t naturally contract Chagas’ disease. His team injected newly fertilized eggs with T. cruzi and found that about a quarter of them incorporated the kDNA into their own DNA. The scientists proved this by breeding kDNA-positive roosters and hens and then their offspring. All the offspring for two generations after the injections turned out positive for kDNA. Those chicks had to get kDNA from their parents’ DNA, since they themselves were never infected with T. cruzi.
Although the chickens passed down kDNA to later generations, this doesn’t mean people inherit Chagas. Most human infections generally occur in childhood, after the embryonic phase of development, which is when the chicks were infected.
It remain unclear how, and even whether, kDNA affects the course of Chagas’ disease. To some scientists, the integration of parasite kDNA into a host’s DNA fits in with an increasingly popular but hotly debated idea that the illness is partly an autoimmune disorder, in which a person’s body attacks its own tissues. When human cells use the genes surrounding incorporated kDNA to make new proteins, the immune system may identify them as coming from the parasite and worthy of attack, speculates Teixeira.
Because kDNA could get into the DNA in many different types of tissues, it may explain why Chagas’ disease affects many organs, says Teixeira.
Other scientists remain skeptical that genomic kDNA integration is even a real phenomenon. “It’s a wild idea, and it’s hard to imagine how it would happen,” says immunologist Rick L. Tarleton of the University of Georgia in Athens. “One would want to see independent confirmation before accepting it.”